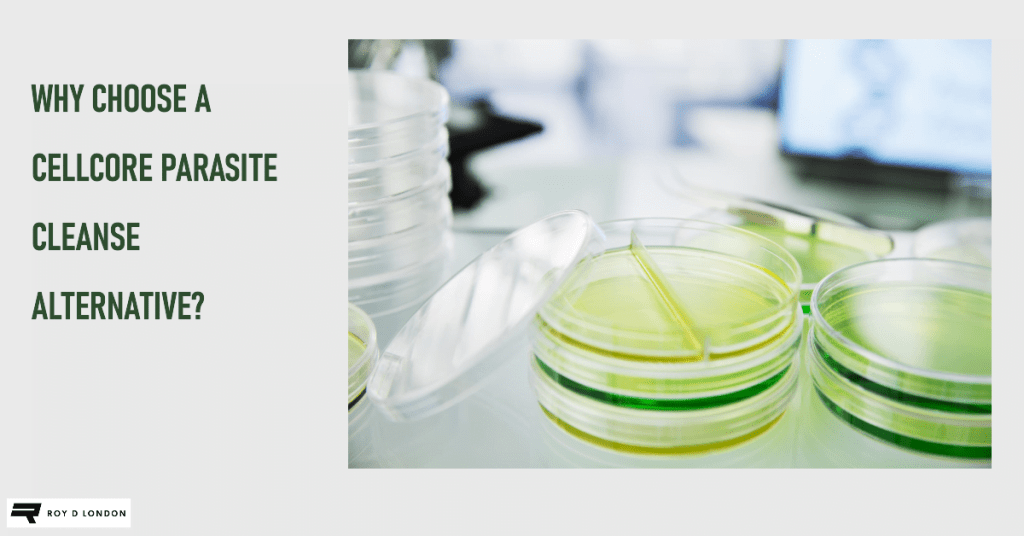
There are two small clear containers on a lab table with a different shade of green liquid in each container. Illustrating why you would choose Cleanest Body Detox as a Cellcore parasite Cleanse alternative.

Best Cellcore Parasite Cleanse Alternative For A Pure Body Detox
This article looks at the Best Cellcore Parasite Cleanse alternative, “Cleanest Body Detox,” which has natural ingredients that promise to rid your body of dangerous parasites, improve overall health, and help with weight loss.ย
It also provides essential vitamins and minerals that your body may miss due to a build-up of toxins, poor diet, or lack of exercise.
Cleanest Body is much better than Cellcore Biosciences detox, Touchstone Essentials, and Pure Body Extra detox. Overall, Cleanest Body is the perfect product to help promote a healthier lifestyle and care for your body’s needs by boosting your body’s natural detoxification processes.
This proprietary blend is also a natural bowel mover aiding in the natural detoxification of unwanted substances in your body and is one of the best life-changing weight loss tips you can quickly start today.
What is Cleanest Body?
Cleanest Body is a revolutionary parasite cleanse and pure body detox program. Helps to rid your body of parasites and other toxins while restoring balance within the digestive system. Advanced technology uses only natural ingredients that are certified organic and have been scientifically proven to be safe for human consumption.
Who is Cleanest Body for?

Cleanest Body parasite detox should be used by:
- Athletes – the best pure body extract to flush their bodies of unwanted parasites that can damage their performance and cause lingering fatigue.
- People who travel frequently, especially to areas where the tap water is unsafe or questionable. Cleanest Body can help to safeguard against gastrointestinal illnesses that can come from drinking contaminated water.
- Outdoor enthusiasts who spend a lot of time in nature or wild places are at greater risk of coming into contact with parasites and may not have access to clean water sources while outdoors. Cleanest Body can help protect them while on the go.
- Those who consume sushi, seafood, and other raw food items that may contain parasites. Regular cleansing with Cleanest Body Detox can reduce the risk of parasitic infections.
- People living in high-risk areas for parasites, such as tropical countries or rural areas, lack access to clean drinking water or sanitation systems.
- Anyone who wants to have better health and longevity. Regular
cleansing/detoxing with the Cleanest Body can help keep parasites away and improve overall health. Making this a perfect body detox for kids and adults.
Cleanest Body Summary
Overall, the Cleanest Body formula is a leading parasite cleansing and weight loss product. This immune health product is designed to be effective, easy to use, and made with natural ingredients. What sets us apart from other companies is that this parasite cleanse is formulated with organic plant extracts that quickly cleanse out parasites without harsh chemicals or side effects.
This weight loss formula also helps people lose weight without giving up their favorite foods. With the Cleanest Body formula, you can get rid of parasites while shedding unwanted pounds and boosting your immune system.
All-Natural
Made from a blend of natural ingredients, such as herbs and fruit extracts, that is gentle on your digestive system.
Detoxify
This is a very effective formula to detox your body and improve nutrient absorption for your body’s natural ability to defend itself.
Reduce
Toxins & weight loss formula activates your system and reduces body weight without strenuous exercise or dieting.
Revitalize
Natural ingredients revitalize your metabolism and energy levels while getting the best nutrition for good health.
Purify
Purifies the body from toxins accumulating over time, making it easier to lose weight overall.
Strengthen
Strengthens your immune system, keeping you healthy and energized so your body naturally can be highly effective.
Cleanest Body
Cons
My Experience With Cleanest Body
Cleanest Body is the perfect solution for anyone looking for a great parasite cleanse, a complete body detox, and an effective weight loss formula. Cleanest Body handles all those needs in one easy-to-use product.
My experience with Cleanest Body has been nothing short of amazing. As someone involved with health and fitness for years, I know how tricky it can be to find the right product that works for you. That is why I was so delighted when I found Cleanest Body โ it does work.
Its all-natural ingredients have enabled me to see results in just a few weeks. Not only this, but the product is free from any harsh chemicals or preservatives that can damage both my body and the environment โ something I’m passionate about.
Using Cleanest Body has empowered me in my health and fitness journey, knowing I’m using a quality product to help me reach my goals. I highly recommend Cleanest Body to anyone looking to take their well-being and gut health seriously. It aids digestion and poor sleep quality, giving you more restful sleep over time of use.
What benefits does Cleanest Body provide?
Here’s a list of benefits that Cleanest Body provides if you’re looking to detox your body and remove toxins and heavy metals to enhance your body’s ability to be healthy:
Benefit #1
Cleanest Body provides a unique, all-natural cleansing for your body. Just like Zuma nutrition, this process is designed to detoxify and rejuvenate your body without harsh chemicals or synthetics. With Cleanest Body, you get a comprehensive cleanse that works quickly and effectively while being gentle on your body.
They have carefully selected these ingredients to provide maximum results without any health risks associated with synthetic cleansers. These natural and organic ingredients make this ideal to ensure your body remains healthy and robust.
Benefit #2
Cleanest Body offers a unique detoxification deep within the cells and body that you would not find anywhere else. This groundbreaking formula contains effective ingredients that help to break down toxins, reduce inflammation, and improve energy levels. It helps to support your overall well-being and health.
In addition, this product is designed to promote a healthy digestive system and flush out any impurities from your body and cells. It helps you feel more energized, refreshed, and balanced daily.
With regular use of Cleanest Body, users will experience improved physical health and overall wellness, which comes from knowing that their bodies are clean from deep within.
Benefit #3
Cleanest Body is a revolutionary product that helps naturally and safely remove toxins, parasites, pollutants, and heavy metals from the body. The product uses a variety of herbs and minerals to create an elixir that can be taken orally. It helps restore balance to the body, allowing it to run at its best.
This balance can reduce stress levels, improve immune function, fight off infectious diseases, and more. With Cleanest Body, you can feel the benefits of reduced toxins and other pollutants quickly and with minimal effort. By removing these substances from your system, youโll experience fewer side effects from environmental toxins like smog or exhaust fumes.
You will also have higher energy levels due to improved detoxification and increased mental clarity due to the body’s ability to process nutrients more efficiently. Cleanest Body provides reduction in toxins, parasites, pollutants, heavy metals etc., so you can enjoy improved health and well-being without sacrificing your lifestyle.
Cleanest Body Pricing – How Much Does it Cost?
Claim Your Discounted Cleanest Body Supply While Stocks Last!
Frequently Asked Questions
Why Choose a Cellcore Parasite Cleanse Alternative?
Choosing a Cellcore Parasite Cleanse alternative might be considered for several reasons: personal health goals, specific dietary needs, or even budgetary considerations. Cellcore Biosciences is known for its comprehensive approach to detoxification and wellness, focusing on removing harmful organisms and toxins from the body. However, some individuals might seek alternatives due to sensitivity to ingredients, preference for a different formulation, or desire a product with a different focus, such as more pronounced immune support or tailored to specific health conditions.
Conclusion – Is Cleanest Body Worth It?
To conclude, unless you can find a way to eat only foods that kill parasites in humans, the Cleanest Body Parasite Detox and Weight Loss formula is a great product to help detox your body and achieve your goals. Not only does it effectively remove parasites from within the body, but it also encourages weight loss and supports cellular repair.
This formula makes for an ideal combination of health benefits for those looking to get back in shape. The product is safe and reliable โ perfect for those who want to keep their body in the best condition to function optimally.
With all these features combined, you can trust the Cleanest Body Parasite detox and weight loss formula for a pure body detox for kids and adults. You will also enjoy other benefits, like increased stomach acid for better digestion, getting rid of brain fog, regulating blood sugar, better liver function, more good bacteria in your gut, and fewer health issues.
Do not wait any longer โ try this fantastic product today and see the excellent results for yourself. Buy now and leave a comment to let us know how much you love the Cleanest Body Parasite detox and weight loss formula.
Check out these must-read articles that are sure to captivate and educate. 75 Best Life-Changing Weight Loss Tips You Can Easily Start Today,
The 5 Best Kangen Water System Alkaline Water Ionizers, 11 Best Exercise Bikes With Arm Workout.
How to Minimize Chronic Pain at Night: Tips for a Restful Sleep.
7 Best Joint Pain Relief Including Joint Restore Gummies & Joint Genesis
5 New Cheaper VR and AR Options: Quality Headsets That Don’t Cost as Much as Apple Vision Pro
AFFILIATE / THIRD-PARTY LINKS: This post may contain affiliate links from programs and businesses whose products and services are of the best quality and standards, in my opinion, if you purchase through these links. I may receive a small commission at no cost to you.









